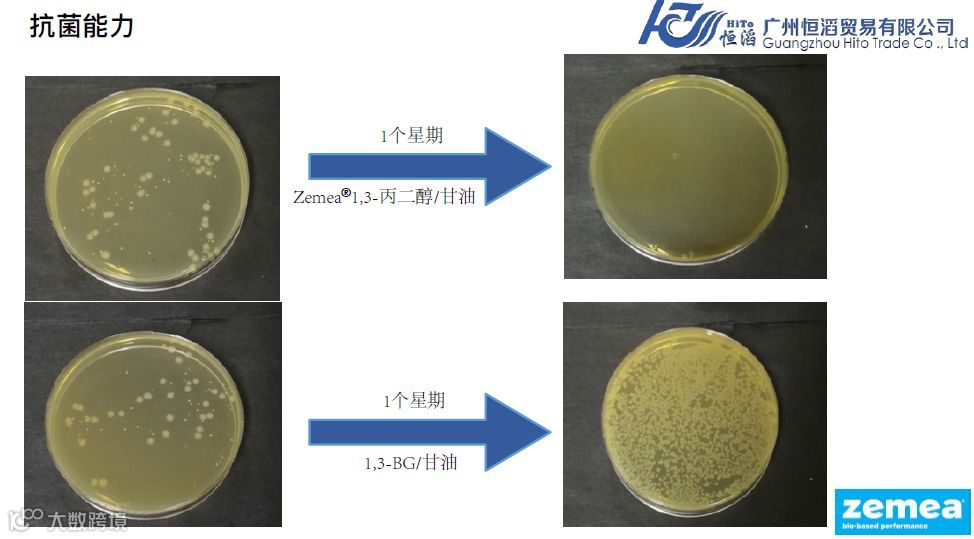
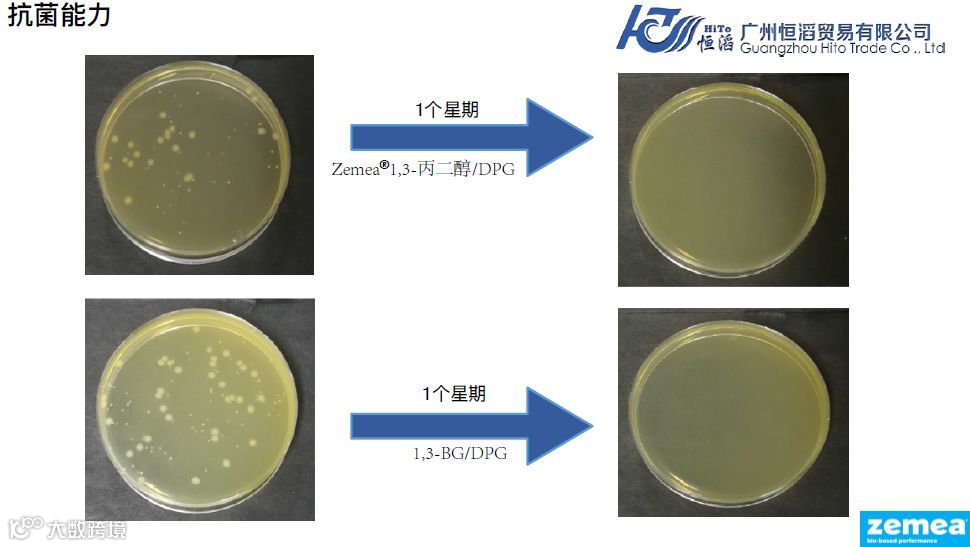
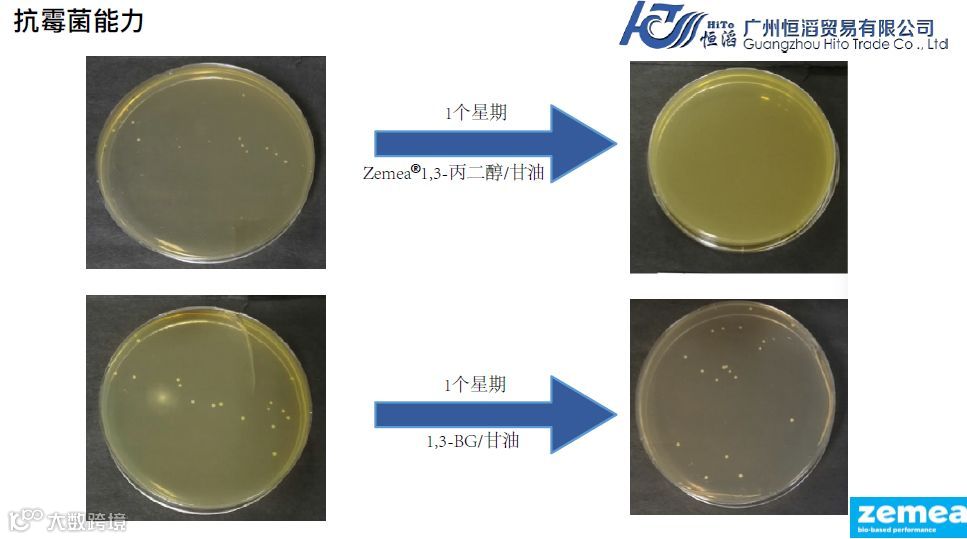
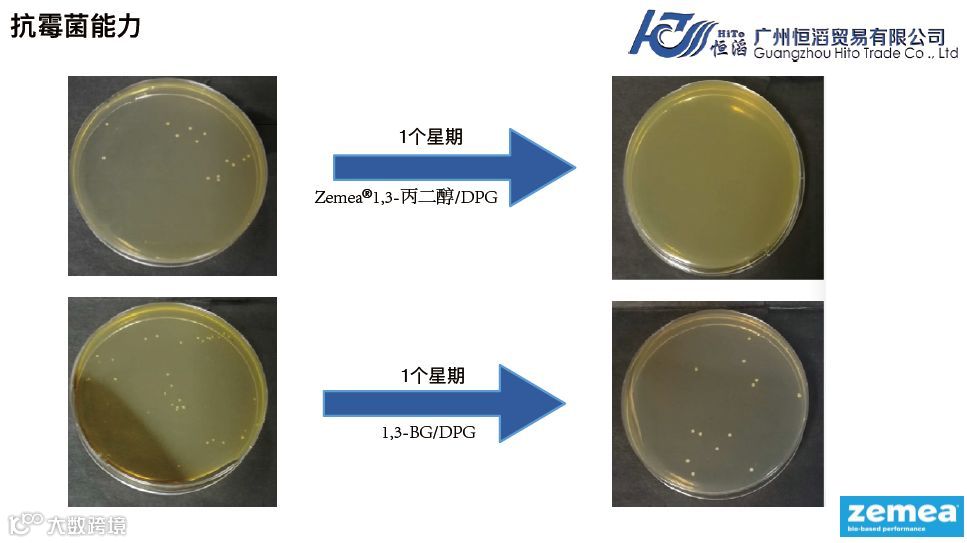

来自杜邦泰特利乐生物产品有限公司的Zemea®1,3-丙二醇,是一种多功能并具有助防腐功效的纯天然保湿剂。Zemea®1,3-丙二醇不仅能满足配方师对原料多功能性的需求,也能满足原料的创新性和市场宣称的特点。另外,Zemea®1,3-丙二醇还可作为一种溶剂,用于各种化妆品和个人护理品配方中。


产品名称:Zemea®Propanediol
Zemea®1,3-丙二醇
INCI名称:Propanediol
效能
-性质温和,对皮肤无刺激性和致敏性
-能提高保湿性能
-天然玉米来源,高纯度,可达99.9%
-具有协同防腐的功效
-卓越的感官性能
-对环境友好

为了让大家更好的深入了解Zemea®1,3-丙二醇这个产品,杜邦泰特利乐公司对这个产品进行了保湿能力的测试、抗菌/抗霉菌能力的测试。
以下是测试的结果:
保湿能力测试
该保湿测试是通过对比Zemea®1,3-丙二醇、DPG以及1,3-BG三者的保湿效果,来确定Zemea®1,3-丙二醇在面膜中是否具备优秀的保湿能力。
在本研究中,我们评估了四个高保湿配方的保湿值,这四个保湿配方含有以下成分:
•Zemea®1,3-丙二醇(10wt.%)
•DPG(10wt.%)
•1,3-BG(10wt.%)
•Zemea®1,3-丙二醇/DPG混合物(各含有5wt.%)


Zemea®1,3-丙二醇在面膜中具备优秀的保湿能力
抗菌/抗霉菌能力测试
采用正交试验,将1,3-BG,Zemea®1,3-丙二醇和DPG以1:1比例混合后再加上透明质酸钠,研究这些组合对抗菌、抗真菌是否具有协同作用。

在抗菌方面,Zemea®1,3-丙二醇/甘油与Zemea®1,3-丙二醇/DPG组合的协同作用效果佳。

在抗霉菌方面,Zemea®1,3-丙二醇/甘油与Zemea®1,3-丙二醇/DPG组合的协同作用效果佳。
★Zemea®1,3-丙二醇在抗菌和抗霉菌方面有显著的效果

如需更多信息或样品
请联系广州恒滔贸易有限公司业务部
电话:020-3923 0182
邮箱:sale@gzhito.com.cn


